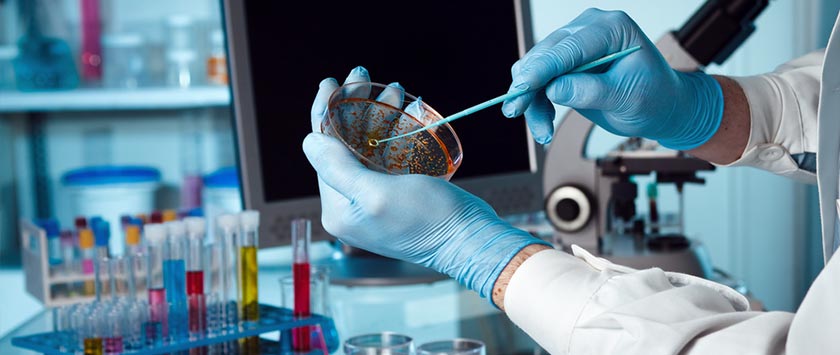

Биотехнологический Лекарственный Комплекс Гебзе МАРТЕК
Стремясь стать лидером в области биотехнологий, Нобел Илач сделал биотехнологию стратегическим приоритетом для улучшения и роста. На протяжении многих лет Нобель предпринимает конкретные шаги и неуклонно продолжает прилагать все усилия для достижения этой цели.
Построенный в Тюбитаке Мармара Текнопарк, Нобель создал один из самых важных и технологически продвинутых биотехнологических фармацевтических объектов в Турции. Объект имеет 800 квадратных метров замкнутого пространства и реактор емкостью 2х1000 литров. Предприятие, которое начало свою деятельность в 2019 году, является единственным предприятием в области разработки биотехнологических клеточных процессов в регионе, которое способно выполнять все функции под его эгидой. Обладая способностью ежегодно производить 4 биотехнологических продукта и производственную мощность 2000 литров, это предприятие может серийно производить 40 биотехнологических препаратов в год и внесет значительный вклад в развитие местного производства в области биотехнологии. Заявка Нобеля на проект «Местная разработка и производство биоаналоговых лекарств», учрежденный TÜBİTAK, была первой среди 23 компаний, подавших 28 заявок в институт. Благодаря новым инвестициям Нобел стремится стать неотъемлемой частью биотехнологической экосистемы.